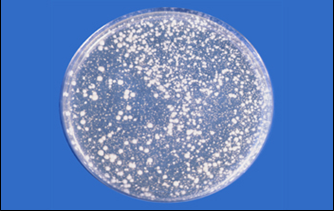
Orange Serum Caf.Agar: Recuento de levaduras y mohos acidófilos.
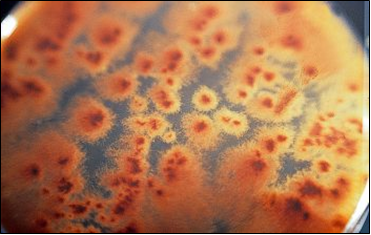
Botrytis cinerea (vista por debajo), alterativo de fresas y uvas y productor del vino noble.

OSMOFILOS ZYGOSACCHAROMYCES YEASTS AGAR OZYA Medio de cultivo para detección y recuento de levaduras osmófilas
Fórmula CENAN mejorada. Medio de cultivo para detección y recuento de levaduras osmófilas, que soportan altas presiones osmóticas, como Zygosaccharomyces rouxi.
COMPOSICIÓN
- Polipeptona micológica 5,0 g
- Extracto de levadura 5,0 g
- Fructosa 250,0 g
- Polisorbato Tween 80 0,75 g
- Agar‑agar 15,0 g
(Fórmula por litro)
pH final: 6,4 ± 0,2
PREPARACIÓN OSMOFILOS ZYGOSACCHAROMYCES AGAR
Disolver 276 g de medio en 1 litro de agua destilada caliente. Calentar agitando hasta ebullición para su disolución. Autoclavar a 116 ºC durante 5 minutos. No sobrecalentar!
MANTENGA EL BOTE BIEN CERRADO EN LUGAR SECO, FRESCO Y OSCURO. AGITE EL BOTE ANTES DE USAR.
PARA USO EXCLUSIVO EN LABORATORIO.
DESHIDRATADO: SÓLO SE PREPARA BAJO PEDIDO EN BIDÓN DE 5 Kg (ó 10 botes de 500 g): DMT225
PREPARADO EN FRASCOS 100ml CÓDIGO: RPL147
CONTROL DE CALIDAD DEL MEDIO
Realizado en nuestro laboratorio; es prudente repetirlo en su laboratorio siempre que varíen las condiciones (más de 3 meses sin usar, tras desinfectar laboratorio, tras conservar a alta Tª, cuando adquiere aspectos extraños aunque no haya llegado la fecha de caducidad teórica de la etiqueta,…)
DESHIDRATADO: Polvo fino, Beige
PREPARADO: Estéril, Paja-Ambar
CONTROL DE CRECIMIENTO 3-5 días a temperatura ambiente (21-28°C aproximadamente):
- Staphylococcus aureus MKTA 6538P, inhibido.
- E.coli MKTA 25922, inhibido.
- Saccharomyces cerevisiae MKTA 9763, Crece con mucha dificultad
- Zygosaccharomyces rouxi MKTN 381, Correcto
PRESENTACIÓN: DESHIDRATADO, FRASCOS PREPARADOS
MODO DE EMPLEO E INTERPRETACIÓN DE RESULTADOS OSMOFILOS ZYGOSACCHAROMYCES AGAR
Fundir al baño María los frascos , sin sobrecalentar. Si se desea, se puede bajar el pH hasta 5,5 con Acido Tartárico estéril para mejorar la selectividad. Si se desea una selectividad total añadir 0,5 g/l de Cloranfenicol.
No recalentar.
Sembrar en masa 1 ml de muestra e incubar 3-7 días a 21-25 ºC aproximadamente, o mejor incubar el tiempo y a la temperatura para los que se puedan esperar problemas (las del almacenamiento y transporte).
El usuario es el único responsable de la eliminación de los microorganismos según la legislación medioambiental vigente. Autoclavar antes de desechar a la basura.
https://www.microkit.es/fichas/OSMOPHILIC-YEAST-AGAR.pdf
Tambien disponible la cepa cuantitativa de Zygosaccharomyces rouxii, a alta concentración para que sirva para Challenge test y también, mediante diluciones, para QC
Si desea más información sobre nuestros OSMOPHILIC ZYGOSACCHAROMYCES YEASTS AGAR OZYA rellene nuestro formulario de contacto http://www.medioscultivo.com/contacto . O si lo prefiere póngase en contacto con nosotros a través de nuestro correo electrónico microkit@microkit.es o por teléfono en el nº 91-897 46 16